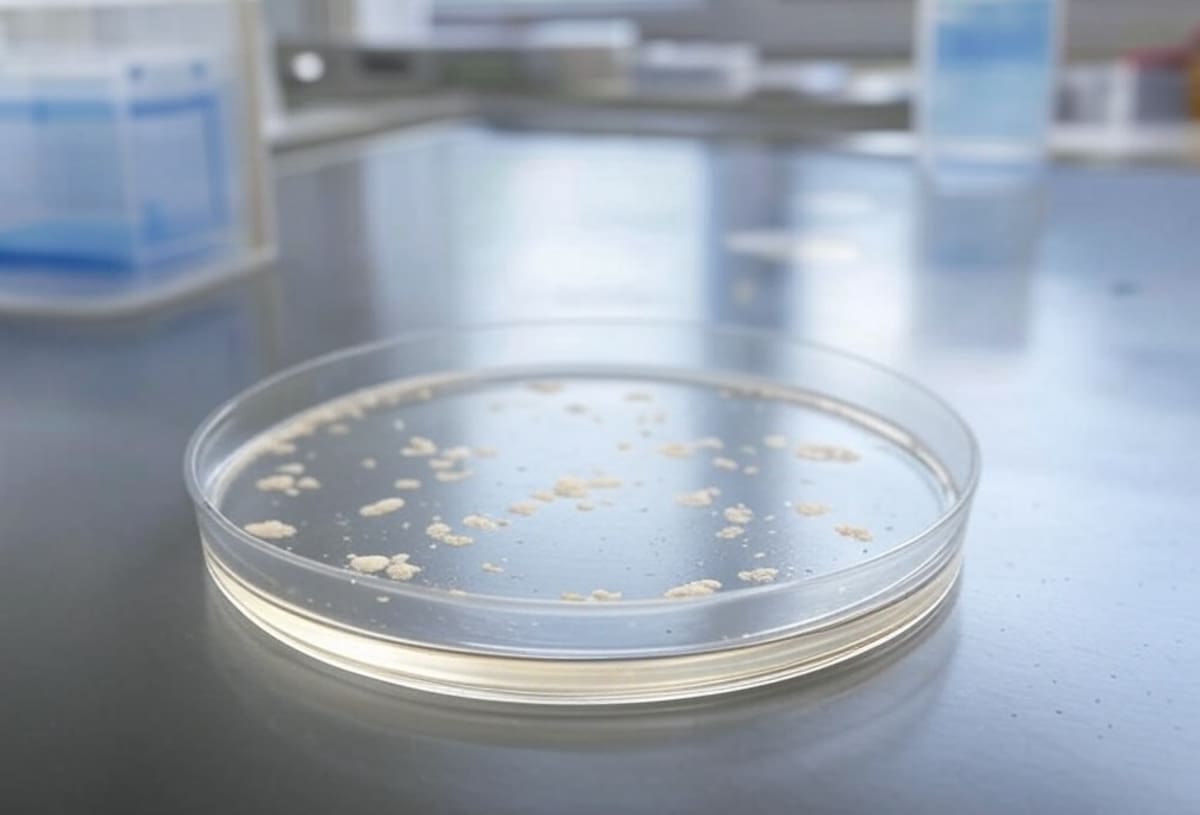
Posteriormente, el patógeno fue trasladado al laboratorio donde trabajaba Jian, en la Universidad de Michigan, con fines de análisis e investigación. Foto: Grok.

Acusan a pareja china de contrabandear hongo con potencial uso agroterrorista en EEUU
El fiscal federal Jerome Gorgan calificó el caso como una amenaza seria para la seguridad nacional.

ESTADOS UNIDOS.- Dos ciudadanos de la República Popular China fueron acusados de introducir de forma ilegal a Estados Unidos un hongo clasificado como potencial arma agroterrorista, informó este martes el Departamento de Justicia.
Según ABC News, el organismo identificó a los sospechosos como Yunqing Jian, de 33 años, y Zunyong Liu, de 34, quienes presuntamente transportaron el microorganismo Fusarium graminearum desde China hasta territorio estadounidense.
De acuerdo con las autoridades, ambos individuos estaban relacionados con instituciones académicas: Jian realizaba investigaciones en la Universidad de Michigan, mientras que Liu, su pareja sentimental, trabajaba en una universidad china donde también investigaba el mismo hongo.
Según el Departamento de Justicia, Jian y Liu recibían fondos del gobierno chino para sus actividades científicas.
La denuncia señala que dispositivos electrónicos de Jian contenían información sobre su afiliación y lealtad al Partido Comunista Chino.
Entrada ilegal a través del aeropuerto de Detroit
Liu admitió, tras inicialmente mentir, haber ingresado Fusarium graminearum al país a través del Aeropuerto Metropolitano de Detroit.
Posteriormente, el patógeno fue trasladado al laboratorio donde trabajaba Jian, en la Universidad de Michigan, con fines de análisis e investigación.
El Buró Federal de Investigaciones (FBI) advirtió que el hongo causa la “tizón de la espiga”, una enfermedad que afecta cultivos clave como el trigo, maíz, arroz y cebada. Esta infección agrícola es responsable cada año de pérdidas económicas multimillonarias a nivel global.
El fiscal federal Jerome Gorgan calificó el caso como una amenaza seria para la seguridad nacional.
“Las presuntas acciones de estos ciudadanos chinos, incluido un miembro leal del Partido Comunista Chino, constituyen una grave preocupación para la seguridad nacional. Estos dos extranjeros han sido acusados de contrabandear un hongo descrito como un ‘arma potencial de agroterrorismo’ en el corazón de Estados Unidos, donde aparentemente pretendían utilizar un laboratorio de la Universidad de Michigan para impulsar su plan”.
Te puede interesar: Tensión entre EEUU y China tras acusaciones de incumplimiento comercial
Proceso judicial en curso
Ambos sospechosos enfrentan cargos federales por contrabando y posibles violaciones a leyes de bioseguridad y espionaje científico.
Las autoridades continúan investigando si otras personas o instituciones están involucradas en esta operación.
El caso ha encendido las alertas sobre los riesgos de biotecnología mal utilizada en contextos internacionales, la vulnerabilidad de los laboratorios académicos frente a amenazas biológicas con implicaciones geopolíticas.
Sigue nuestro canal de WhatsApp
Recibe las noticias más importantes del día. Da click aquí
Te recomendamos

Estados Unidos anunció la operación “Lanza del Sur”, una ofensiva militar del Pentágono contra presuntos narcoterroristas en Latinoamérica

Exagente de la DEA es acusado de lavar dinero y buscar armas para el Cártel Jalisco Nueva Generación; enfrenta cargos de narcoterrorismo

El secretario de Defensa Pete Hegseth anunció la “Operación Lanza del Sur” contra el narcoterrorismo, pero no explicó su alcance ni su relación con los ataques a presuntas narcolanchas y se avivan dudas sobre un posible giro militar hacia Venezuela

Atacante de la Guardia Nacional sería afgano: lo que se sabe del tiroteo cerca de la Casa Blanca


Grupo Healy © Copyright Impresora y Editorial S.A. de C.V. Todos los derechos reservados